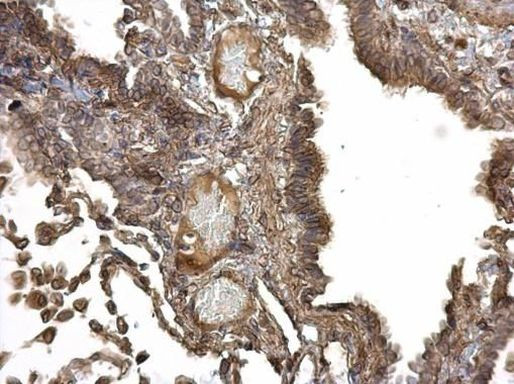
IGF1R Antibody in Immunohistochemistry (Paraffin) (IHC (P))

Search
Invitrogen
IGF1R Polyclonal Antibody
{{$productOrderCtrl.translations['antibody.pdp.commerceCard.promotion.promotions']}}
{{$productOrderCtrl.translations['antibody.pdp.commerceCard.promotion.viewpromo']}}
{{$productOrderCtrl.translations['antibody.pdp.commerceCard.promotion.promocode']}}: {{promo.promoCode}} {{promo.promoTitle}} {{promo.promoDescription}}. {{$productOrderCtrl.translations['antibody.pdp.commerceCard.promotion.learnmore']}}

Please note: We are reviewing Western blot images included in the antibody testing data in our catalog, including those provided by third parties. Unless expressly labeled or annotated as “raw-unedited”, Western blot images included in the antibody testing data in our catalog may have been edited, optimized or otherwise adjusted for presentation.
产品信息
PA5-29351
宿主/亚型
分类
类型
抗原
偶联物
形式
浓度
规格
保存条件
运输条件
产品详细信息
PA5-29351 targets IGF1 receptor in WB applications and shows reactivity with Human and mouse samples.
The PA5-29351 immunogen is recombinant fragment corresponding to a region within amino acids 199 and 447 of Human IGF1 receptor.
靶标信息
IGF1R, also known as Insulin-like Growth Factor 1 (IGF-1) Receptor, is a receptor tyrosine kinase activated by IGF-1 and IGF-2. IGFR has been implicated in a variety of cancers. The protein is a tetramer consisting of two alpha, and two beta subunits. The alpha-subunits binds to insulin growth factor 1 with higher affinity than to insulin growth factor 2. Binding results in a conformational change, followed by autophosphorylation of IGF-1R at positions 1134, 1135, 1136. The activated IGF-1R in turn, causes phosphorylation of substrate proteins, followed by sequential activation of RAS, RAF, and mitogen-activated protein kinase isoforms ERK, p38, and JNK, leading to the transcription of genes that drive proliferation.
⚠WARNING: This product can expose you to chemicals including mercury, which is known to the State of California to cause birth defects or other reproductive harm. For more information go to www.P65Warnings.ca.gov.
仅用于科研。不用于诊断过程。未经明确授权不得转售。